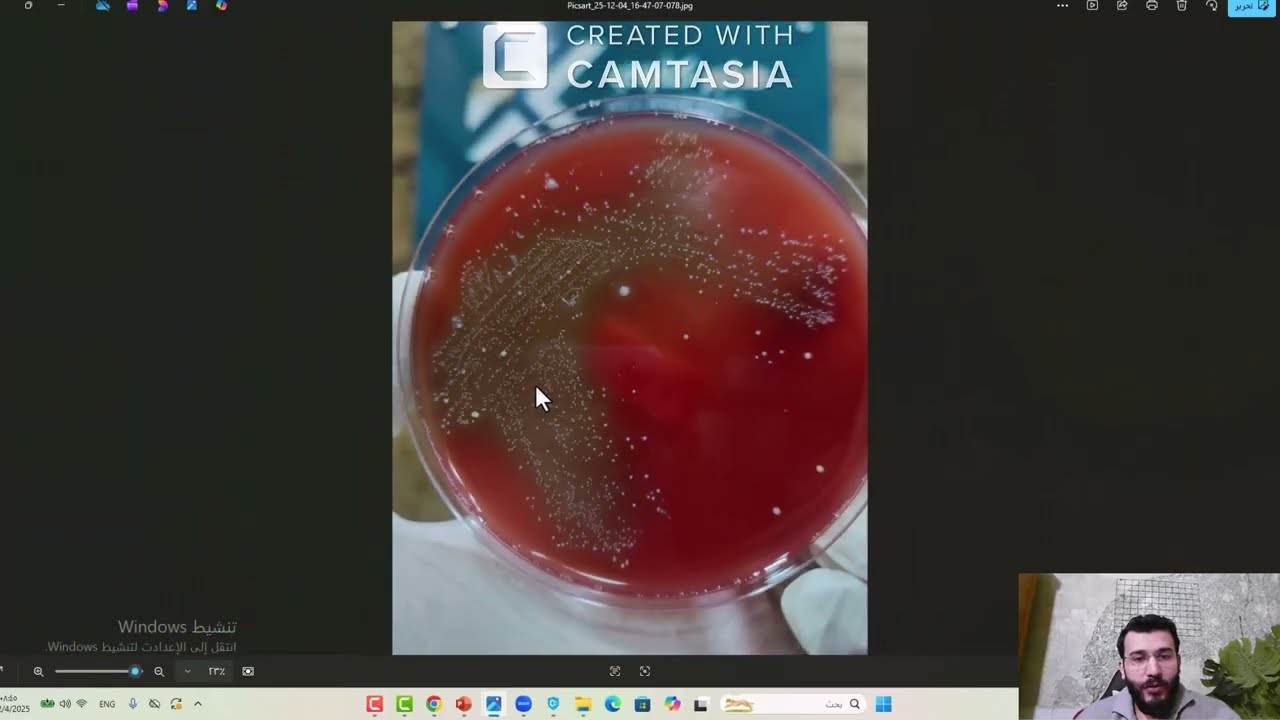
blood agar-الاغار الدموي

blood agar-الاغار الدموي скачать в хорошем качестве
Повторяем попытку...
Скачать видео с ютуб по ссылке или смотреть без блокировок на сайте: blood agar-الاغار الدموي в качестве 4k
У нас вы можете посмотреть бесплатно blood agar-الاغار الدموي или скачать в максимальном доступном качестве, видео которое было загружено на ютуб. Для загрузки выберите вариант из формы ниже:
-
Информация по загрузке:
Скачать mp3 с ютуба отдельным файлом. Бесплатный рингтон blood agar-الاغار الدموي в формате MP3:
Если кнопки скачивания не
загрузились
НАЖМИТЕ ЗДЕСЬ или обновите страницу
Если возникают проблемы со скачиванием видео, пожалуйста напишите в поддержку по адресу внизу
страницы.
Спасибо за использование сервиса ClipSaver.ru
blood agar-الاغار الدموي
ل تعلم أن طبقًا واحدًا قادر على كشف سلوك البكتيريا بدقة؟ الآغار الدموي ليس مجرد وسط زرعي، بل أداة تشخيصية أساسية تكشف نمط التحلل الدموي وتساعد في التفريق بين أنواع الجراثيم المهمة سريريًا مثل Streptococcus و Staphylococcus. في هذا الريل نشرح: ما هو الآغار الدموي؟ أنواع التحلل الدموي (α – β – γ) أهميته في التشخيص المخبري أخطاء شائعة يجب الانتباه لها #drwaleedkllawe #د.وليد_كلاوي #زرع_جرثومي



















